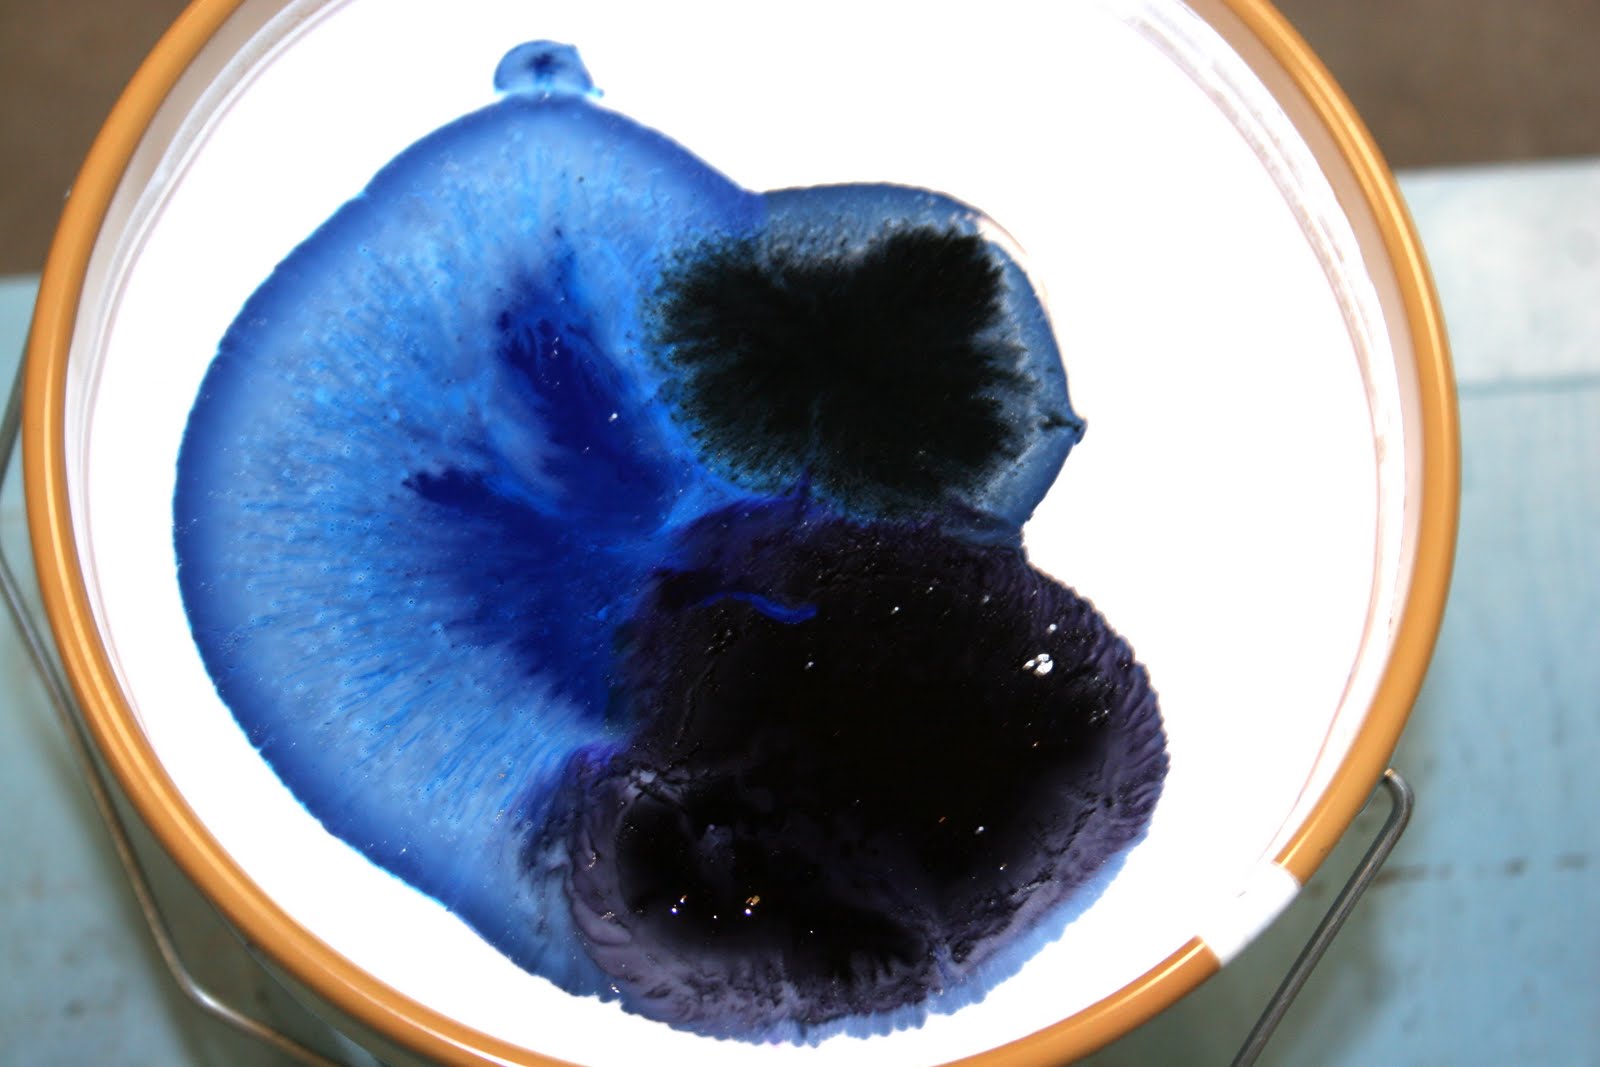

Right now we are floating between houses. We are still trying to sell our Charlotte house and we still stay at the “flop” house as Ella calls it. I had intended on painting the flop house, but life has seriously gotten in the way. So I’m going to do this post in 2 parts. I know lots of people start home projects at the first of the year and if you are going to paint, you must read this article first!
VOC’s are volatile organic compounds which are in most paints. First of all, Low or No VOC paint is basically a joke. If you purchase the expensive No VOC paint and then add color, 25% VOC just got added back into the paint. On top of that, the government allows the use of certain chemicals (which are actually VOC’s but do not cause smog) to be called “exempt compounds” and they are not to be applied as VOC’s. So the paint has them, but the brand can still write No VOC or Low VOC on their label. The government does not care about toxicity or safety of the paint. They only rate VOC’s due to their reaction to nitrous oxides and ultra violet light to form low level ozone, or smog.
The government allows 250 grams of VOCS per liter of regular paint. That’s almost half a pound! Green Seal GS-11 paints can have 150 grams per liter (besides flat paint which is 50 grams). And No VOC can have 5 grams per liter. This is only the VOC’s that aren’t exempt. Who knows what the true levels are once you factor those in!
The American Lung Associate says that VOS’s can produce a number of health problems like eye and skin irritations, lung and breathing problems, headaches, nausea, muscle weakness, liver and kidney damage. It is recommended that you do not paint while pregnant and that it can cause a miscarriage or deformities. It is not known exactly how long the VOC’s can emit into the air, but it is speculated the paint can release emissions for years after the initial application. The best thing to do is to buy non-toxic paint like ECOS Paints.
The world’s best selling water based, VOC Free paint
Solvent-free, Glycol-free, Eco-friendly, Allergy-safe finishes
Totally free of all pesticides, herbicides and toxins
![]()
–>
- Quality without compromise
- 7000x Purer than the latest European 2010 Standards
- Ultimate Purity: VOC Free, Glycol Free, Solvent Free, Odor Free
- No dubious chemicals: EN71 compliant
- All ingredients declared
- Non Yellowing and Entirely Non-Toxic
- Minimize Your Carbon Footprint : Act on CO2
ECOS Paints are made up of:
- water, natural plus manufactured binders (all water-based, all non-toxic)
- pigments (yellow ochre, red ochre, various – all non toxic)
- mineral fillers – limestone, clays (non-toxic)
- thickeners & builders – wood cellulose & resinous (all non-toxic)
- white pigment – titanium dioxide (food grade – non-toxic)
- levellers (all non-toxic)
- waxes & texture powders (all non-toxic)
I got to tour the USA ECOS Paints factory in November which was a lot fun! I love the owners, who are an amazing husband and wife team, and learned so much. I was even able to bring Ella and didn’t have to worry about her inhaling toxic fumes.  When I walked into the factory you couldn’t even tell that they made paint.
When I walked into the factory you couldn’t even tell that they made paint.  Even the huge barrels that were filled with paint didn’t smell.
Even the huge barrels that were filled with paint didn’t smell.  I learned that the company started in the UK 22 years ago by a chemist who was allergic to chemicals! So creating a chemical free paint was the perfect project. When authorities came to test out his paint to make sure ECOS was actually non-toxic, they told him to prove it. So, he actually took a spoon and ate a sample of paint. Remember, he is allergic to chemicals, so this could have killed him! Luckily it didn’t and ECOS Paints is still going strong.
I learned that the company started in the UK 22 years ago by a chemist who was allergic to chemicals! So creating a chemical free paint was the perfect project. When authorities came to test out his paint to make sure ECOS was actually non-toxic, they told him to prove it. So, he actually took a spoon and ate a sample of paint. Remember, he is allergic to chemicals, so this could have killed him! Luckily it didn’t and ECOS Paints is still going strong. ECOS Paints are solvent and VOC free. They use non-toxic pigments which can create 108 standard paint colors (or match your color) Below is a picture of the pigments used.
ECOS Paints are solvent and VOC free. They use non-toxic pigments which can create 108 standard paint colors (or match your color) Below is a picture of the pigments used.  It’s really cool that they place the can of paint on a scale and then read from a book how many grams of each colour they need to add to make the standard colour. This is great so will get the same exact colour if you need more in the future.
It’s really cool that they place the can of paint on a scale and then read from a book how many grams of each colour they need to add to make the standard colour. This is great so will get the same exact colour if you need more in the future.
Then the paint is taken to the shaker to be mixed to the colour you desire.
Then the paint is taken to the shaker to be mixed to the colour you desire. Ella loved helping mix the colours! After the colour is mixed, it is written down and a colour swatch is painted so if you need to order more, you will definitely get the exact match!
Ella loved helping mix the colours! After the colour is mixed, it is written down and a colour swatch is painted so if you need to order more, you will definitely get the exact match! ECOS Paints has paint for walls, wood, floors, masonry, and specialist paints. I think the specialist paints are amazing! They have a Air-Purifying Paint that basically traps toxins in the paint and doesn’t release them back into the air. A friend of mine bought a foreclosure that had been used as a meth lab. This would have been perfect to absorb the toxins! ECOS also has a Nursery Paint that is built to last many inevitable cleanings.
ECOS Paints has paint for walls, wood, floors, masonry, and specialist paints. I think the specialist paints are amazing! They have a Air-Purifying Paint that basically traps toxins in the paint and doesn’t release them back into the air. A friend of mine bought a foreclosure that had been used as a meth lab. This would have been perfect to absorb the toxins! ECOS also has a Nursery Paint that is built to last many inevitable cleanings.
There is so much more to say about ECOS Paints, so I will be back with a second post. And with my painting remodel when life has settled. Until then, I hope you check them out. They are an amazing company!
